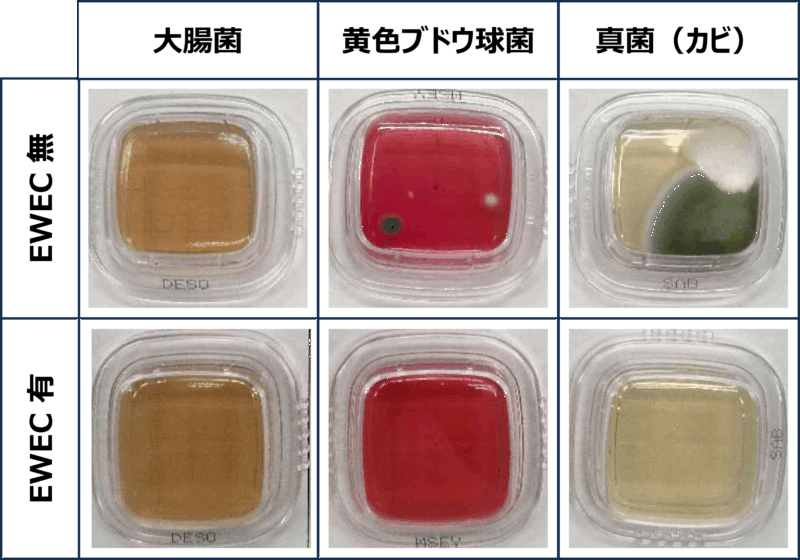

この度はAurarikaのサイトをご覧いただき誠にありがとうございます。
お問い合わせは下記のフォームにご記入をお願い致します。
お問い合わせ
この度はAurarikaのサイトをご覧いただき誠にありがとうございます。
お問い合わせは下記のフォームにご記入をお願い致します。

ヒノキチオールは、自然由来でありながら非常にユニークな化学構造と多機能性を持つ成分で、リラクゼーション効果以外に抗菌・抗カビ・抗炎症・美肌効果などでも注目されています。
ヒノキと名前はついていますが、実はヒノキには多くは含まれずヒバの木に多く含まれます。ヒバは日本固有の樹木であり、青森ヒバは木曽ヒノキ、秋田スギと並ぶ日本三大美林のひとつです
ヒノキチオールには以下の効果が報告されています。
1.リラックス効果(森林浴効果)
吸入すると副交感神経が優位となり、ストレスホルモンの低下や心拍数の安定を促す。住空間に木質建材を取り入れるだけで、深い癒しが得られる。
2. 抗菌作用
強い抗菌力を持ち、カビ・細菌・一部ウイルスの増殖を抑制します。
特に虫歯菌(ミュータンス菌)や黄色ブドウ球菌などに有効性が報告されています。
化粧品や歯磨き粉、防腐剤などに応用されています。
3. 防腐・防カビ作用
木材の保存剤として利用されることが多いです。
ヒノキチオールを含む木材は腐朽菌に強く、防腐性が高いため建築資材や家具に応用されます。
ヒノキチオールによる空間の抗クロカビ効果は自社でも確認しています。
4. 消臭・空気清浄効果
悪臭成分に吸着・分解作用を示し、屋内外の空気を浄化します。
ハンガーや畜舎の敷料に利用されています。
5. 抗炎症作用
炎症を抑える効果が報告されており、皮膚の赤み・かゆみの軽減に役立つことがあります。
化粧水や歯磨きに配合される例があります。
6. メラミン生成抑制による美白効果
7. 育毛・頭皮環境改善
血行促進作用や抗菌作用により、頭皮環境を整え、抜け毛予防や育毛促進が期待されるとして育毛剤に配合されます。
8. 防虫作用
ダニやシロアリに対して忌避効果があるとされ、木材保護や生活環境衛生に応用されています。
ムカデなどにも効果があるという報告もあります。
9. 抗酸化作用
活性酸素を抑える作用があるとされ、細胞の酸化ストレス軽減につながると研究されています。
化粧品のエイジングケア成分として利用されています。
10. その他
上記以外も抗腫瘍作用、細胞賦活作用、サーチュイン(長寿遺伝子)活性化作用などの報告も見られます
このような多様な効果から、主に医薬部外品や衛生用品、化粧品、育毛剤、木材保存、工業用途にも使われています。
会社名
ストーフジャパン合同会社
事業者の名称
永原煌基
事業者の所在地
〒225-0024
神奈川県横浜市青葉区市ケ尾町1050-35
事業者の連絡先
045-755-5950
営業時間・ショップ情報など
営業時間:9:00-17:00
定休日:土日祝
販売価格
販売価格は、税込み表記となっております。
また、別途配送料が掛かる場合もございます。配送料に関しては商品詳細ページをご確認ください。
代金の支払方法・時期
支払方法:クレジットカードによる決済がご利用いただけます。
支払時期:商品注文確定時にお支払いが確定いたします。
Pay ID あと払い:
・ コンビニ:ご請求後翌月10日のお支払い:支払い手数料:350円(税込)
・ 口座振替:ご請求後指定口座より引き落とし:支払い手数料:無料
銀行振込決済(ご請求後5営業日以内のお支払い):
支払い手数料:360円(税込)
商品のお届け時期
代金のお支払い確定後、5日以内に発送いたします。
後払い決済の場合は注文確定後、5日以内に発送いたします。
返品について
商品に欠陥がある場合をのぞき、基本的には返品には応じません。
当ショップは、お客様の個人情報保護の重要性について認識し、個人情報の保護に関する法律(以下「個人情報保護法」といいます。)を遵守すると共に、以下のプライバシーポリシー(以下「本プライバシーポリシー」といいます。)に従い、適切な取扱い及び保護に努めます。
1. 個人情報の定義
本プライバシーポリシーにおいて、個人情報とは、個人情報保護法第2条第1項により定義された個人情報、すなわち、生存する個人に関する情報であって、当該情報に含まれる氏名、生年月日その他の記述等により特定の個人を識別することができるもの(他の情報と容易に照合することができ、それにより特定の個人を識別することができることとなるものを含みます。)、もしくは個人識別符号が含まれる情報を意味するものとします。
2. 個人情報の利用目的
当ショップは、お客様の個人情報を、以下の目的で利用致します。
3. 個人情報利用目的の変更
当ショップは、個人情報の利用目的を、関連性を有すると合理的に認められる範囲内において変更することがあり、変更した場合にはお客様に通知又は公表します。
4. 個人情報利用の制限
当ショップは、個人情報保護法その他の法令により許容される場合を除き、お客様の同意を得ず、利用目的の達成に必要な範囲を超えて個人情報を取り扱いません。但し、次の場合はこの限りではありません。
5. 個人情報の適正な取得
当ショップは、適正に個人情報を取得し、偽りその他不正の手段により取得しません。
6. 個人情報の安全管理
当ショップは、個人情報の紛失、破壊、改ざん及び漏洩などのリスクに対して、個人情報の安全管理が図られるよう、当ショップの従業員に対し、必要かつ適切な監督を行います。また、当ショップは、個人情報の取扱いの全部又は一部を委託する場合は、委託先において個人情報の安全管理が図られるよう、必要かつ適切な監督を行います。
7. 第三者提供
当ショップは、個人情報保護法その他の法令に基づき開示が認められる場合を除くほか、あらかじめお客様の同意を得ないで、個人情報を第三者に提供しません。但し、次に掲げる場合は上記に定める第三者への提供には該当しません。
当ショップは、2. 個人情報の利用目的(3)に定められた目的のために以下の提供先に対して外国(本邦の域外にある国又は地域をいいます)にある広告配信業者に個人情報を提供することがあります。
■ Meta Platforms, Inc.(米国・カリフォルニア州)
8. 個人情報の開示
当ショップは、お客様から、個人情報保護法の定めに基づき個人情報の開示を求められたときは、お客様ご本人からのご請求であることを確認の上で、お客様に対し、遅滞なく開示を行います(当該個人情報が存在しないときにはその旨を通知いたします。)。但し、個人情報保護法その他の法令により、当ショップが開示の義務を負わない場合は、この限りではありません。
9. 個人情報の訂正等
当ショップは、お客様から、個人情報が真実でないという理由によって、個人情報保護法の定めに基づきその内容の訂正、追加又は削除(以下「訂正等」といいます。)を求められた場合には、お客様ご本人からのご請求であることを確認の上で、利用目的の達成に必要な範囲内において、遅滞なく必要な調査を行い、その結果に基づき、個人情報の内容の訂正等を行い、その旨をお客様に通知します(訂正等を行わない旨の決定をしたときは、お客様に対しその旨を通知いたします。)。但し、個人情報保護法その他の法令により、当ショップが訂正等の義務を負わない場合は、この限りではありません。
10. 個人情報の利用停止等
当ショップは、お客様から、お客様の個人情報が、あらかじめ公表された利用目的の範囲を超えて取り扱われているという理由又は偽りその他不正の手段により取得されたものであるという理由により、個人情報保護法の定めに基づきその利用の停止又は消去(以下「利用停止等」といいます。)を求められた場合において、そのご請求に理由があることが判明した場合には、お客様ご本人からのご請求であることを確認の上で、遅滞なく個人情報の利用停止等を行い、その旨をお客様に通知します。但し、個人情報保護法その他の法令により、当ショップが利用停止等の義務を負わない場合は、この限りではありません。
11. Cookie(クッキー)その他の技術の利用
12. お問い合わせ
開示等のお申出、ご意見、ご質問、苦情のお申出その他個人情報の取扱いに関するお問い合わせは、当ショップの「特定商取引法に基づく表記」内にある連絡先へご連絡いただくか、ショップページ内のお問い合わせフォームよりお問い合わせください。
13. 継続的改善
当ショップは、個人情報の取扱いに関する運用状況を適宜見直し、継続的な改善に努めるものとし、必要に応じて、本プライバシーポリシーを変更することがあります。